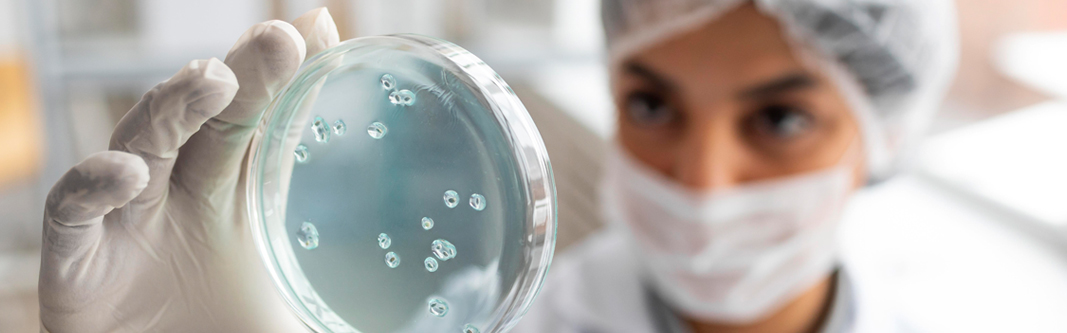

PRODUCT
-
Agar
-
Seaweed Powder
-
Carrageenan
-
Konjac Glucomannan
-
Stabilizer
-
Others
APPLICATION
HISTORICAL ALGARIUM
CONTACT
SEARCH
Seaweed Powder
Carrageenan
Konjac Glucomannan
Stabilizer
Others
SEARCH
clear
-
-
 APPLICATION
APPLICATION - Beverages
- Condiments
- Bakery
- Dairy
- Confectionery
- Meat & Poultry
- Water Gel
- Packaged Food
- Plastic Substitutes
- Pet Food
- Plant Tissue Culture
- Bacteriological
- Pharmaceutical
- Cosmetic
-
- SEAWEED POWDER
- phytaFIBER
-
- CARRAGEENAN
- kappa KR
- kappa KR PES
-
- KONJAC GLUCOMANNAN
- viscoILES
- javaSENSE PGM
-
- STABILIZER
- JB CRYSTALGEL
- JB FRUITO
- JB ICECREMO
- JB CONDIPRO
- JB YOGPRO
-
- OTHERS
- DERMOGLUCOSAMINE
Product

BACTOagar in bacteriological grade agar extracted from cultivated red seaweed (Class
Rhodophyceae), for microbiological culture media.
Suggested for the following application: culture media for microbiological purpose.
Rhodophyceae), for microbiological culture media.
Suggested for the following application: culture media for microbiological purpose.
SUGGESTED FOR THE FOLLOWING APPLICATIONS:
Bacteriological
AVAILABLE IN:

INDONESIA
OFFICE & MANUFACTURING PLANT
Sikatan 39, SurabayaIndonesia, 60175
T: +6231 355 1221
ITALY
OFFICE & MANUFACTURING PLANT
Via Giovanni e Sebastiano Caboto 19/7, Trieste Italy 34147T: +39 040 2038 587
Java
Biocolloid
Biocolloid
BACK TO TOP
Java
Biocolloid
Biocolloid
BACK TO TOP
INDONESIA
OFFICE & MANUFACTURING PLANT
Sikatan 39, SurabayaIndonesia, 60175
T: +6231 355 1221
ITALY
OFFICE & MANUFACTURING PLANT
Via Giovanni e Sebastiano Caboto 19/7, Trieste Italy 34147T: +39 040 2038 587
Java Biocolloid and Java Biocolloid Europe are part of Hakiki Group
©2025 Java Biocolloid. All Right Reserved. Website design by Lencanna Branding
©2025 Java Biocolloid. All Right Reserved. Website design by Lencanna Branding
Thank You!
Success!
You have been subscribed in our list.
Sorry!
Failed to subscribe!
Please fix errors below:

